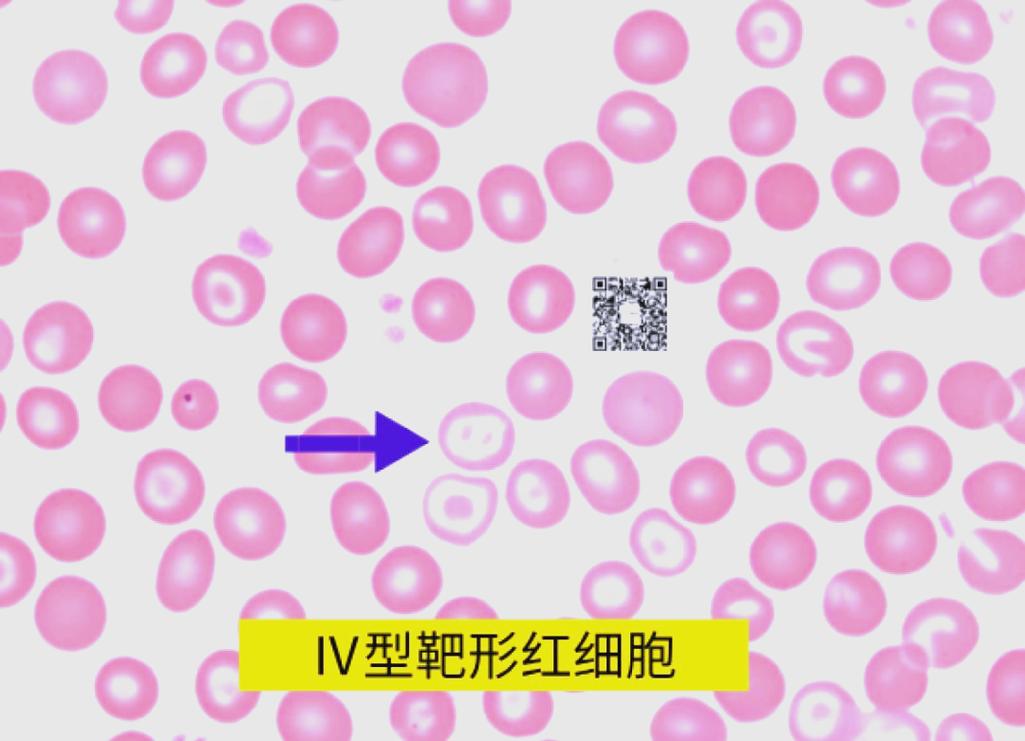
失明 脑梗 靶向细胞

第一部分:分别理解三个概念
失明
失明是指视觉功能严重受损或完全丧失,导致无法看到物体,其原因多种多样,主要可以分为两大类:

(图片来源网络,侵删)
- 视网膜及视神经疾病: 这是导致不可逆失明的主要原因,因为感光细胞受损后无法再生。
- 年龄相关性黄斑变性: 老年人失明的首要原因,损伤视网膜中心区域(黄斑)的感光细胞。
- 视网膜色素变性: 遗传性疾病,导致感光细胞和色素上皮细胞逐渐退化。
- 青光眼: 眼压升高损伤视神经,导致视觉信号无法传递到大脑。
- 糖尿病视网膜病变: 糖尿病并发症,损伤视网膜血管,导致缺血和细胞死亡。
- 大脑视觉中枢疾病: 眼睛和视神经是健康的,但负责处理视觉信息的大脑区域(如枕叶的视觉皮层)受损,导致失明,这被称为皮质性盲。
- 脑梗 就是导致皮质性盲的最常见原因之一。
脑梗
脑梗,全称“脑梗死”或“缺血性脑卒中”,是指因脑部血管阻塞,导致局部脑组织缺血、缺氧而发生坏死。
- 病因: 最常见的是血栓形成(血管内壁血栓堵塞血管)或栓塞(身体其他部位的血栓或斑块脱落,随血流堵塞脑血管)。
- 影响: 脑细胞对缺氧极其敏感,一旦血流中断,几分钟内就会开始死亡,坏死的脑细胞功能会永久丧失。
- 与失明的联系: 如果供应枕叶视觉皮层的血管(如大脑后动脉)发生梗塞,该区域负责处理视觉信息的功能就会丧失,尽管患者的眼睛能接收光线,视神经也能将信号传递到大脑,但大脑“处理中心”坏了,所以依然会失明或出现视野缺损(例如偏盲),这就是皮质性盲。
靶向细胞
这是一个广义的概念,指的是能够特异性地识别并结合到特定目标细胞(如病变细胞、特定类型的细胞)上的技术或方法。
- “靶向”是关键: 就像导弹制导一样,能精确命中目标,而不损伤周围的健康组织。
- 实现方式:
- 靶向药物: 如抗癌药物“靶向药”,能识别癌细胞表面的特定蛋白(如HER2),从而只杀死癌细胞,减少对正常细胞的伤害。
- 基因治疗: 利用病毒载体(如AAV)作为“快递车”,将健康的基因递送到特定的细胞中,以修复缺陷基因。
- 细胞治疗: 将健康的细胞(如干细胞)输送到体内,并让它们精准地迁移到受损部位进行修复。
第二部分:三者之间的关联与前沿治疗
我们将这三个概念串联起来,看看它们在医学上是如何交织在一起的。
核心关联:脑梗导致的失明 vs. 眼部疾病导致的失明
治疗策略截然不同:
(图片来源网络,侵删)
-
针对脑梗导致的皮质性盲:
- 传统方法: 溶栓、取栓(恢复血流)、康复训练(如视觉再训练,利用大脑可塑性来代偿部分功能),但已经坏死的脑细胞无法再生。
- 前沿探索(靶向细胞的应用):
- 神经保护与修复: 在脑梗发生后,利用靶向技术将具有神经营养和保护作用的干细胞(如间充质干细胞)或神经前体细胞输送到受损的脑区,希望能保护残存的神经元,促进血管再生,甚至刺激内源性神经干细胞分化。
- 挑战: 大脑环境复杂,要让移植的细胞精准地迁移到视觉皮层并正确整合到现有的神经网络中,难度极大,目前大多处于动物实验阶段。
-
针对眼部疾病(如AMD、RP)导致的失明:
- 这是“靶向细胞”技术最活跃、最有希望突破的领域! 因为眼睛是一个相对“免疫豁免”和易于操作的器官。
- 治疗思路: 既然是感光细胞死亡,那就“补上”这些细胞。
- 前沿疗法(干细胞与基因治疗的结合):
- 干细胞疗法:
- 方法: 在体外将干细胞(如胚胎干细胞或诱导多能干细胞 iPSC)诱导分化成感光细胞或视网膜色素上皮细胞。
- “靶向”体现: 通过精细的手术,将这些新生的细胞精准地移植到患者视网膜的受损区域,这本身就是一种空间上的“靶向”。
- 目标: 移植的细胞能与剩余的视网膜细胞建立连接,恢复部分光信号转换功能。
- 进展: 全球已有多个团队完成了相关临床试验,部分患者视力得到显著改善,甚至恢复了阅读能力,但仍面临免疫排斥、细胞存活率和长期安全性等问题。
- 基因编辑与靶向基因治疗:
- 方法: 对于由特定基因突变(如RP的某些类型)引起的失明,可以利用CRISPR-Cas9等基因编辑技术,在体外修复患者的干细胞,再分化移植;或者直接将修复好的基因通过病毒载体(靶向工具)递送到患者视网膜特定的细胞中。
- “靶向”体现: 病毒载体被设计成只能感染视网膜的特定细胞(如感光细胞),从而将治疗基因精准地送达“病灶”。
- 进展: 这类药物(如Luxturna)已经获批上市,用于治疗特定类型的遗传性视网膜病变,是“靶向细胞/基因治疗”的成功典范。
- 干细胞疗法:
第三部分:总结与展望
| 特征 | 脑梗导致的失明 | 眼部疾病导致的失明 |
|---|---|---|
| 病变部位 | 大脑视觉皮层 | 眼睛(视网膜、视神经) |
| 核心问题 | 神经元细胞群永久性坏死 | 感光细胞/支持细胞永久性死亡 |
| 传统治疗 | 恢复血流、康复训练 | 药物延缓进展、手术并发症处理 |
| 靶向细胞/基因治疗策略 | 修复大脑: 输送干细胞/神经营养因子,修复复杂的神经网络。难度极高。 | 替换细胞/修复基因: 移植新的感光细胞或修复致病基因。难度相对较低,进展最快。 |
| 当前阶段 | 主要处于临床前研究和早期探索阶段 | 已有药物上市,多个干细胞疗法进入临床验证阶段,前景光明。 |
“失明”、“脑梗”和“靶向细胞”这三个词描绘了现代医学挑战与希望并存的图景。
- 脑梗是导致皮质性失明的常见原因,其治疗难点在于修复大脑内复杂且脆弱的神经网络。
- 靶向细胞技术,特别是干细胞疗法和基因疗法,为治疗因视网膜细胞死亡导致的失明带来了革命性的希望,并已取得实质性突破。
- 对于脑梗后的失明,靶向细胞技术仍在探索中,面临着如何让细胞在复杂的大脑环境中精准存活、迁移和整合的巨大挑战。
虽然脑梗导致的失明治疗更为困难,但靶向细胞技术为我们提供了前所未有的思路去攻克这些过去被认为“不可逆”的致盲性疾病,随着材料科学、基因编辑和干细胞技术的不断成熟,这些疗法将变得更加精准、安全和有效。




